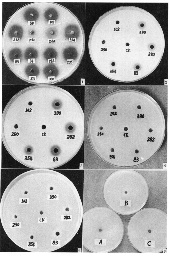
JWXT1996030050001_s

【作者】周而勋;王克荣;陆家云;
【机构】南京农业大学植保系;南京农业大学植保系 南京 210095;
【摘要】对栗疫病菌不同毒力菌株产生胞外酶的种类、活性和草酸产量以及草酸对多聚半乳糖醛酸酶水解聚果胶酸钙的影响进行了研究。所有供试菌株均未能检测到淀粉酶活性。栗疫病菌在培养中可分泌漆酶、多聚半乳糖醛酸酶、蛋白酶、纤维素酶和脂酶,但不同毒力菌株产生这些酶的能力不同。总的来说,强毒力菌株均可分泌这些酶,且活性强,但弱毒力菌株的酶活性较弱或不分泌这些酶。菌丝产量和草酸产量分析表明,强毒力菌株的草酸产量明显高于弱毒力菌株。菌丝产量与草酸产量没有相关性。在没有草酸盐存在的条件下,多聚半乳糖醛酸酶不能降解聚果胶酸钙。
ManBetX体育栗疫病菌;胞外酶;草酸盐;弱毒力;dsRNA;
【基金】国家自然科学基金;
【分类号】S432;
【文内图片】